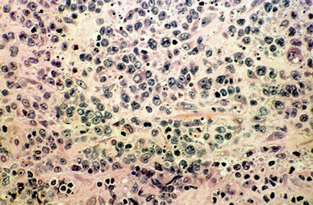

Rheumatoid arthritis is a common disorder. Its various articular and extra-articular manifestations are well described, but less well known is the association between rheumatoid arthritis and malignancy. There is an intrinsic risk of lymphoma, particularly non-Hodgkin's lymphoma, in rheumatoid arthritis. In determining causality, it is difficult to separate the effects of treatment from those of the disease itself — most patients with rheumatoid arthritis are treated with more than one immunosuppressive agent during the course of their disease. Cyclosporin has been implicated in the development of lymphoma, predominantly in association with transplantation.1,2 In addition, there are an increasing number of reports of B-cell lymphomas in rheumatoid arthritis patients that would seem to implicate methotrexate.3-10
A 63-year-old white man with seropositive rheumatoid arthritis presented to our outpatient clinic with a 4-week history of right hip and buttock discomfort. He described a deep ache, with no radiation. The pain was worse on weight-bearing and during the night. He had had mild fevers, and had lost 7 kg in weight over the previous 2 months.
His rheumatoid arthritis had been difficult to control in the 10 years since the initial diagnosis, and at the time of presentation his medications were methotrexate 20 mg weekly, cyclosporin 125 mg twice daily, sulfasalazine 1 g three times daily, and hydroxychloroquine 200 mg daily. He does not have Sjögren's syndrome. Intercurrent medical conditions included bronchiectasis since childhood and interstitial lung disease secondary to rheumatoid arthritis.
Examination revealed painful restriction of movement of the right hip and swelling of the right buttock. Mild synovitis was present in the hands, shoulders, neck and knees. He also had clubbing, bilateral basal crepitations and splenomegaly (all longstanding). There was no lymphadenopathy.
The erythrocyte sedimentation rate and C-reactive protein level were elevated at 84 mm/h (normal range, 0–14 mm/h) and 100 mg/L (normal range, < 10 mg/L), respectively. He had normocytic anaemia, with a haemoglobin level of 103 g/L (normal range, 130–180 g/L). His white cell count and platelet count were normal, as were liver function test results and electrolyte levels. His creatinine level had risen from 110 mol/L to 180 mol/L (normal range, 50–90 mol/L) over 3 months. Cyclosporin was stopped because of his worsening renal function.
Radiography of his hips, pelvis and lumbosacral spine revealed mild degenerative changes only. A bone scan showed increased uptake in the region of the right buttock, right sacroiliac joint and the superior aspect of the right acetabulum. Computed tomography (CT) scan revealed diffuse swelling involving the right gluteus medius and piriformis muscles (Box, Figure 1). Magnetic resonance imaging (Box, Figure 2) confirmed these findings, but also showed swelling of the obturator internus and part of the gluteus maximus muscles, as well as some increased signal in the right iliac bone seen on T1-weighted images.
Tissue from the right gluteus medius muscle was obtained by open biopsy. Histological examination revealed diffuse infiltration of malignant lymphoid cells (Box, Figure 3), with positive immunoperoxidase staining for the leukocyte common antigens CD20 and CD79. A diagnosis of diffuse large B-cell, non-Hodgkin's lymphoma was made.
Staging (CT of the chest, abdomen and pelvis; bone marrow biopsy; and gallium scanning) revealed no other sites of lymphoma. Serological tests for HIV gave negative results. The malignant cells were negative for Epstein–Barr virus DNA by polymerase chain reaction.
When the diagnosis was established, methotrexate was also stopped. The patient presented for CHOP-based chemotherapy (cyclophosphamide, adriamycin, vincristine, prednisolone) 19 days later (2 months after he stopped taking cyclosporin). The palpable swelling of the right buttock had disappeared, and a repeat CT scan confirmed resolution of the previously diffuse muscle swelling (Box, Figure 4). Chemotherapy was withheld.
Fifteen months later, there has been no recurrence. His rheumatoid arthritis flared when he was taking sulfasalazine and hydroxychloroquine, and is being managed with combination corticosteroids and non-steroidal anti-inflammatory medication.
Patients with rheumatoid arthritis have been reported to have a two- to threefold increased risk of lymphatic cancer (eg, non-Hodgkin's and Hodgkin's lymphoma).3,4 The suggestion that disease-modifying drugs further increase this risk is controversial, as it is difficult to match patients for disease severity. Disease activity may, in itself, be a risk factor for development of lymphoma,5 and, because more potent immunosuppressive agents are used in more severe disease, there may not be a true relationship between treatments and lymphoma.
However, lymphoma in patients taking cyclosporin in association with transplantation is well described, with a 28-times-higher prevalence.1 There is a predominance of non-Hodgkin's lymphoma, and suggestive evidence that Epstein–Barr virus plays a role in the aetiology of some of these lymphomas, with documented remission on reduction or cessation of the immunosuppressive therapy.2
There are an increasing number of reports of lymphoma in patients treated with methotrexate for rheumatoid arthritis.6-8 Extranodal involvement is common, occurring in 69% of cases, although, in contrast to findings in AIDS patients and patients having transplantation, high frequencies of brain involvement have not been found.6 The predominant lymphoma type is large B-cell, non-Hodgkin's lymphoma. Epstein–Barr virus has been found in the lymphoma cells in 41% of cases.6
The strongest causal link is spontaneous lymphoma remission after stopping methotrexate. This has been documented in at least 15 patients with rheumatoid arthritis,6-8 with remission occurring within 4 weeks of stopping the drug. Therefore, a period of observation without immunosuppressive treatment is mandatory.
Given the widespread use of methotrexate in rheumatoid arthritis, the number of reported cases is small. The increased risk of lymphoma in rheumatoid arthritis patients treated with methotrexate is probably real, but it is a low risk. It has been suggested that this effect of methotrexate and of cyclosporin occurs only in the subgroup of rheumatoid arthritis patients who already have severely disturbed immunity.7,9,10 Immunosuppressive treatment may lead to even poorer oncogenic surveillance and the survival of a malignant clone. As combination therapy, such as methotrexate and cyclosporin, becomes more widespread, physicians will have to be more aware of the potential for lymphoma.
- Irwin G S Lim1
- James V Bertouch2
- 1 Department of Rheumatology, Royal North Shore Hospital, St Leonards, NSW.
- 2 Department of Rheumatology, Prince of Wales Hospital, Randwick, NSW.
- 1. Cockburn ITR, Krupp P. The risk of neoplasms in patients treated with cyclosporine A. J Autoimmunity 1989; 2: 723-731.
- 2. Penn I. Cancers following cyclosporine therapy. Transplantation 1987; 43: 32-35.
- 3. MacFarlane GJ, Black RJ. Rheumatoid arthritis and lymphatic cancer. Eur J Cancer 1996; 32A: 1630-1632.
- 4. Gridley G, McLaughlin JK, Ekbom A, et al. Incidence of cancer among patients with rheumatoid arthritis. J Natl Cancer Inst 1993; 85: 307-311.
- 5. Baecklund E, Ekbom A, Sparen P, et al. Disease activity and risk of lymphoma in patients with rheumatoid arthritis: nested case-control study. BMJ 1998; 317: 180-181.
- 6. Georgescu L, Paget SA. Lymphoma in patients with rheumatoid arthritis. What is the evidence of a link with methotrexate? Drug Safety 1999; 20: 475-487.
- 7. Georgescu L, Quinn GC, Schwartzman S, Paget SA. Lymphoma in patients with rheumatoid arthritis: association with the disease state or methotrexate treatment. Semin Arthritis Rheum 1997; 26: 794-804.
- 8. Kono H, Inokuma S, Matsuzaki Y, et al. Two cases of methotrexate induced lymphomas in rheumatoid arthritis: an association with increased serum IgE. J Rheumatol 1999; 26: 2249-2253.
- 9. Ferraccioli GF, Casatta L, Bartoli E, et al. Epstein–Barr virus-associated Hodgkin's lymphoma in a rheumatoid arthritis patient treated with methotrexate and cyclosporin A. Arthritis Rheum 1995; 38: 867-868.
- 10. Kremer JM. Is methotrexate oncogenic in patients with rheumatoid arthritis? Semin Arthritis Rheum 1997; 26: 785-787.